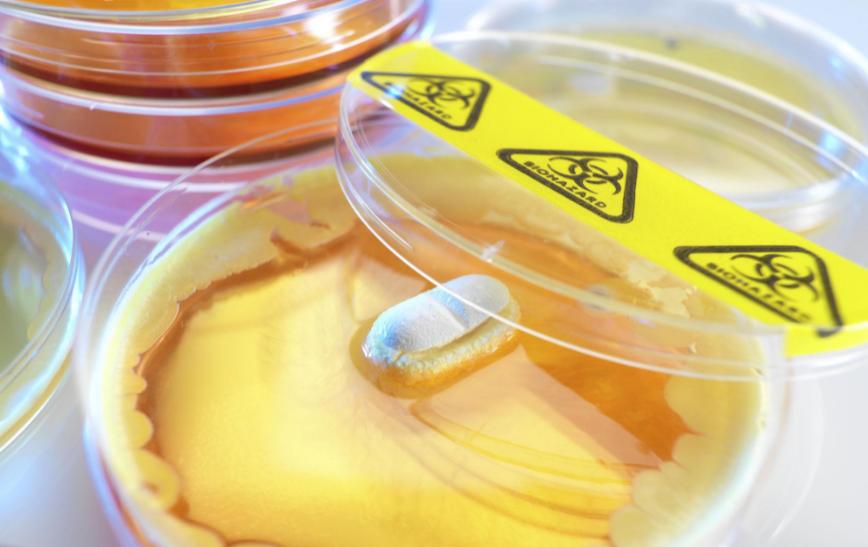
甲硝唑一瓶100片,甲硝唑一瓶100片和24粒哪个好
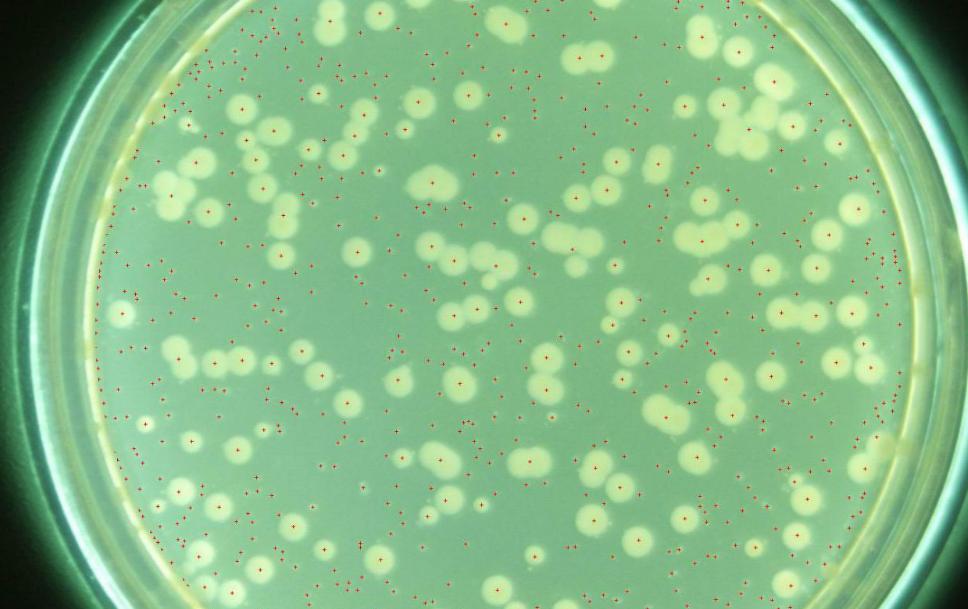
甲硝唑一瓶100片,甲硝唑一瓶100片和24粒哪个好

任先生,今年45岁,最近上腹部,总是出现胀痛不适感,在通过食用胃肠药物后,经过2-3小时以后,胃部不适的症状依旧没有改善,反而出现恶心与呕吐的症状,紧急到医院就医。
医生给任先生检测幽门螺旋杆菌,C-14呼气后,结果呈现阳性,并在做了胃镜与肠镜检查之后,发现任先生有非常严重的胃溃疡,并告知他,出现的症状,可能是因为感染幽门螺旋杆菌,引起的急性胃溃疡,建议立即使用“四联药物”,来进行幽门螺旋杆菌的根除治疗,并且通过修复胃粘膜的方式,来治疗急性胃溃疡。
而其中四联药物,就包括甲硝唑,但是任先生就非常疑惑:甲硝唑不是用来治牙痛的吗?怎么会还用来治疗幽门螺旋杆菌?

一、甲硝唑明明治牙痛,为何对于幽门螺旋杆菌具有治疗效果?
甲硝唑,属于硝基咪唑类的抗生素,常用于治疗因厌氧菌感染,或滴虫感染的各项病症。
而厌氧菌是什么?它是一种只能在无氧的环境下,生长的一种细菌或微生物,而甲硝唑,对大多数厌氧菌具有良好的抗菌作用。
我们要知道,幽门螺旋杆菌,也属于一种厌氧革兰阴性细菌。它是目前唯一,可以在胃高强酸的环境下,存活的一种细菌。 根据《世界卫生组织》的研究表明,幽门螺旋杆菌与人体,多项常见的胃部疾病有相关,例如慢性食管炎、萎缩性胃炎、非萎缩性胃炎等,而且幽门螺旋杆菌有多项,明确会对于人体产生致癌风险的直接证据,因此,被列为第1级致癌物。

更为可怕的是,幽门螺旋杆菌起初在感染时,并没有什么特别的症状,可能只会表现轻微的胃部闷痛或胃部胀气,等到幽门螺旋杆菌在胃部大量的复制以后,就会使胃部的黏膜,产生发炎的现象,甚至导致病变。
因此,目前在消化内科,在进行胃镜与肠镜检查时,也会要求患者进行幽门螺旋杆菌的检查,来确认是否有幽门螺旋杆菌感染,方便进行下一步的诊治与制定治疗方案。
而当患者,出现幽门螺旋杆菌感染时,医生通常会开立四联药物来进行治疗,包括两种抗生素如甲硝唑、阿莫西林、奥美拉唑肠溶胶囊、胶体果胶铋等药物。
其中,甲硝唑,对于幽门螺旋杆菌,这类的厌氧菌,具有抑制其生长与繁殖的作用,再加上阿莫西林的共同杀菌作用,同时再联合奥美拉唑肠溶胶囊,可以用来抑制胃酸的过度分泌,具有保护胃黏膜的作用,更能有效修复胃黏膜,达到治疗的目的。
二、甲硝唑竟还能治这3种常见病?
甲硝唑,其实不光对厌氧菌具有显著的抗菌效果,对于治疗滴虫感染,也具有显著作用,所以又被称作灭滴灵,而甲硝唑还可用来治疗的疾病,给大家总结如下:
1.牙周发炎
经过研究证实,在患有牙周炎的患者当中,有85%的患者,是因为牙周感染牙龈卟啉单胞菌,所引起的发炎症状。
而牙龈卟啉单胞菌,是一种厌氧性的革兰氏阴性球杆菌,此种细菌常生长并黏附在牙周上面,甚至与其他的细菌种类,如金黄色葡萄球菌、乳酸杆菌,在牙周的表面上,共同形成菌斑生物膜,引起牙周长期的发炎。
更为可怕的是,因为菌斑生物膜,具有较厚的防护层,以及黏附性,因此,无法通过日常的漱口还有刷牙清除,而当菌斑生物膜一直在牙周上不断累积,变得更厚或面积扩大时,菌斑生物膜会与唾液中的矿物质(如钙质)进行结合,形成牙结石,从而造成更加严重的病症,如牙龈出血、牙龈萎缩等。

此时,必须通过牙医,利用洗牙,或是去除牙结石手术,来进行清除,否则,就会引起更严重的症状。
另外,因为卟啉单胞菌,会在牙周上,不断的产生多种毒力因子,除了会造成上述的症状以外,还有可能会通过血液循环,到达脑部组织,并且促使脑部的细胞,产生一种叫做牙龈蛋白酶的毒素酶体,这种毒酶,会快速破坏脑部的组织结构,造成脑细胞死亡,甚至多项实验研究已经证实,这种毒酶与人体罹患阿尔茨海默病,具有非常重要的联系。
因此,牙龈卟啉单胞菌不光会造成牙周发炎,还有可能会引起脑部的严重疾病,所以,在目前治疗牙周炎上,主要的治疗方式,就是根除牙龈卟啉单胞菌这类的厌氧菌,来达到治疗的目的。
而甲硝唑,可以干扰牙龈卟啉单胞菌体内正常的DNA合成,使细菌DNA的代谢功能,出现严重障碍,引起细菌的自然凋亡,当细菌在牙周上大量的凋亡以后,就能使牙周的发炎情况,顺利获得改善。因此,甲硝唑常被用来使用杀灭牙龈卟啉单胞菌,进而治疗牙周炎。
2.皮肤*疮痤**
*疮痤**,是皮肤科的常见疾病。引起皮肤*疮痤**的原因,有80%的患者,是因感染*疮痤**丙酸杆菌所导致,其是一种革兰性厌氧菌,常寄生于我们人体的皮肤毛囊以及皮脂腺上。
当皮肤,因为长期的内分泌失调,以及食用过多的油脂类饮食时,会使皮肤的表面产生过多的油脂,而这些油脂,可能会引起,皮肤表面的毛孔堵塞,导致皮肤无法通过空气中获得足够的氧气。

而*疮痤**丙酸杆菌喜欢生长在缺氧的环境当中,所以更有助于*疮痤**丙酸杆菌的大量生长,造成皮肤中的毛囊以及皮肤腺的发炎,从而堵塞皮肤毛孔,导致皮肤红肿,形成皮肤表面上,红肿丘疹状的发炎肿块,也就是皮肤*疮痤**。
而甲硝唑,可用于抑制*疮痤**丙酸杆菌在皮肤中的活性,通过改变*疮痤**丙酸杆菌DNA正常的生成速度,导致其凋亡,减少皮肤上的*疮痤**丙酸杆菌数量,从而改善皮肤*疮痤**的症状。
3.滴虫性阴道炎
在妇科疾病当中,滴虫性阴道炎是一种常见的感染性疾病,是由阴道滴虫感染从而你产生的相关病症。
当患者阴道感染滴虫后,有45-50%的比率初期没有任何症状,等到阴道滴虫在阴道中大量繁殖以后,才会出现黄绿色,且呈现大量泡沫状甚至会产生大量的恶臭分泌物。

此时,患者的阴道已经被大量的阴道滴虫所感染,而阴道滴虫会吞噬阴道上皮细胞糖原,阻碍乳酸的生成,使阴道的PH上升,破坏原本阴道中的菌种平衡,导致其他的病原体,如金黄色葡萄球菌、霉菌等,又因为阴道的环境被破坏以后,这些病原体会在阴道内不断的繁殖与生长,进而导致急性阴道发炎等症状。
更为可怕的是,阴道滴虫不只寄生于阴道,还常会侵入尿道或尿道旁腺,导致尿道发炎,而使患者排尿时,出现尿道口红肿热痛、尿频、血尿的症状,因此,患有阴道滴虫的患者,除了会出现大量的分泌外以外,还有可能会造成泌尿系统疾病。
因为阴道滴虫可通过日常的生活习惯,以及*生活性**进行传播,例如与伴侣之间共享毛巾、牙具等,甚至通过*行为性**进行传播,所以,当夫妻双方有一方患有滴虫感染时,都会建议一起进行治疗。

而甲硝唑,可以通过抑制,阴道滴虫体内的DNA活性,使其体内中的染色体结构,慢慢地被破坏,以致阴道滴虫逐渐凋亡,导致其无法在体内大量的复制,因此改善阴道内的炎症反应,使症状慢慢的恢复与改善。所以,甲硝唑才会常常应用于妇科疾病。
三、甲硝唑在使用时,出现2种情况,建议先停药!
甲硝唑,在通过上述的介绍以后,大家知道其对于牙周发炎、皮肤*疮痤**,以及阴道滴虫,均有显着效果,而因为其药效显着且药价便宜,所以是一种使用率很高的药物,而这些使用的患者,在使用甲硝唑后,会出现一些副作用与不良反应,这些反应,总结如下:

1.转氨酶出现升高
因为甲硝唑,在人体当中,主要的代谢途径,是通过肝脏的代谢,所以,当本身肝脏功能不佳的患者,使用甲硝唑后,可能会出现转氨酶的升高。
因此,对于患有慢性乙肝或丙肝等患者,甚至是其他严重的肝病人群,并不建议自行到药房或网上购买甲硝唑进行使用。务必到医院先检查肝功能后,通过医生的评估,来确认是否可以使用甲硝唑来治疗症状。
2.恶心呕吐
甲硝唑,因为属于厌氧菌类的抗生素,此种药物的化学结构,会导致身体的中枢神经出现问题。
而因为人体中的呕吐中枢,位于脑干中的延髓,因此,使用甲硝唑后,可能会影响到中枢神经功能运转出现问题,进而导致延髓的功能出现错乱,引起呕吐中枢出现异常,使得患者产生恶心呕吐的症状。
不过,此种症状,一般在患者通过停止使用后,恶心呕吐的感受都会慢慢的缓解,因此,患者无需过于担心,若真的在使用后出现恶心呕吐的症状时,请立即停止服用药物,并马上就医。

四、甲硝唑别乱用!以下2点一定要注意!
甲硝唑,虽然在临床上使用普遍程度相当高,大家也都对它相当的熟悉,但是在使用甲硝唑时,依旧是有相关的注意事项以及禁忌症需要特别去关注:
1.孕妇禁止使用甲硝唑
孕妇在妊娠期,是不可以使用甲硝唑来治疗症状的,因为通过多项的实验证实,当孕妇在妊娠期间,服用甲硝唑后,会导致畸胎的风险大幅提高。
甚至,哺乳期的妇女,也不可以使用甲硝唑,因为若哺乳的母亲,在分泌乳汁旺盛的时期,利用甲硝唑来治疗疾病时,甲硝唑可能会通过血液循环,运送至母亲的乳房当中,从而使乳房分泌的乳汁,含有甲硝唑。
而当母亲哺喂乳母给孩子食用时,甲硝唑就会连同乳汁,一同进到胎儿的体内,造成胎儿的脑部发育出现问题,因此,禁止妊娠期以及哺乳期妇女,使用甲硝唑治疗症状。

2.使用甲硝唑时禁止饮酒
酒精进入人体代谢的时候,肝脏中的乙醇脱氢酶,会将酒精转换为乙醛,再经由肝脏中的乙醛脱氢酶,将乙醛转换成乙酸,最后再将乙酸转化为碳酸和水,最后通过尿液排除体外。
而双硫仑本身是一种戒酒药物,当患者饮用双硫仑以后,会抑制肝脏中乙醛脱氢酶的代谢功能,从而使患者体内的乙醛无法被转换为乙酸,大量的乙醛会囤积在肝脏中,患者就容易产生恶心呕吐等症状,临床上正是利用此药理作用,来让患者害怕饮用酒精,从而达到戒酒的效果,此作用被称作为双硫仑反应。
而在临床上很多的治疗药物,与双硫仑这种戒酒药物,有类似的化学结构,因此,也具有抑制乙醛脱氢酶的作用,当服用后,可能会导致患者出现,相同的恶心呕吐等症状。

而甲硝唑就是属于此种药物,当服用甲硝唑后,又与酒精同时进入到人体内,就会产生双硫仑反应。因此,在服用甲硝唑时,千万不可与酒精一起并用,否则会产生,非常严重的双硫仑反应,影响到生命安全,那就非常得不偿失了。
结语
希望通过本文的这些内容,让大家可以真正的了解甲硝唑,更多的信息,能够在使用此药物时,掌握到更多的正确使用方式,来达到药物的最高安全性,就是本文撰写的最高期望,若您对本文内容有疑问想多了解,欢迎您在底下留言或咨询,一起深入探讨。